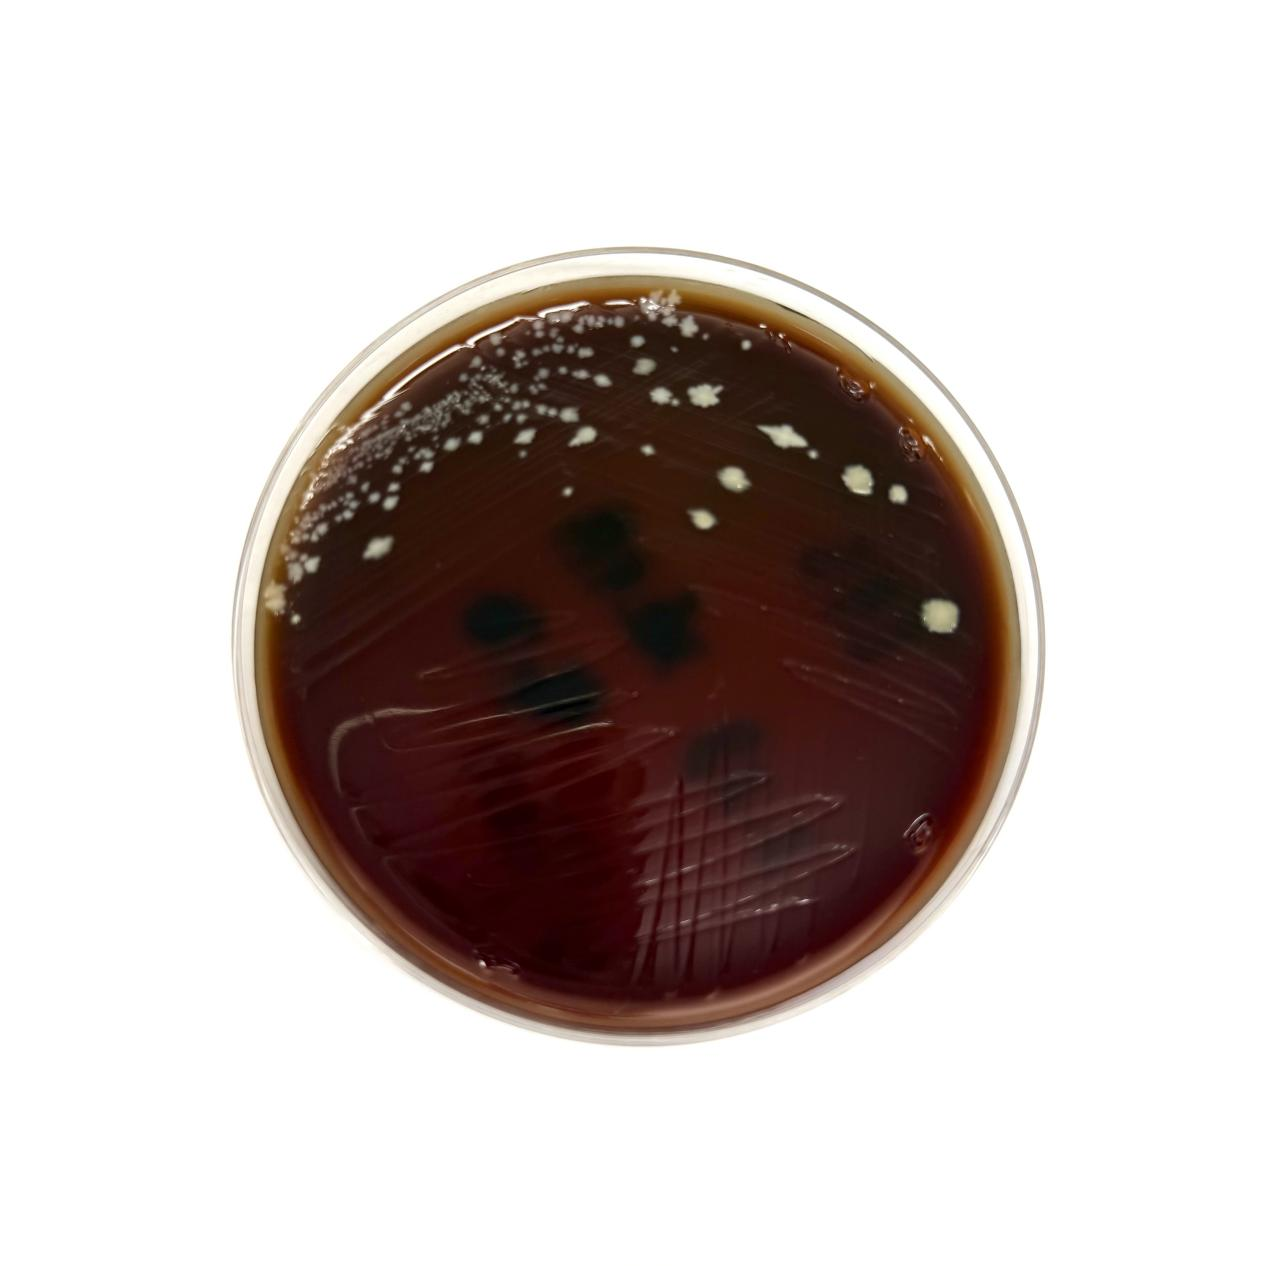

从一场腹泻说起
赵阿姨因肺炎住院,使用抗生素治疗一个月后,虽然肺部感染好转,却突然出现严重的腹痛、腹泻,一天内腹泻次数高达7-15次。起初只是水样便,后来竟出现脓血便。经检查,医生发现她感染了“艰难梭菌”。这个听起来陌生的细菌究竟是什么?为何在抗生素治疗后“趁虚而入”?让我们通过赵阿姨的案例,揭开它的神秘面纱。
1、身份揭秘
艰难梭菌是一种厌氧菌,在分离培养的过程中对分子氧非常敏感,需严格的厌氧环境才能生长繁殖,以其难以培养的特性得名“艰难”。它既存在于人类和动物的肠道中,也能以芽孢的形式在环境中长期存活,尤其是医院的地面、床栏、马桶等区域,成为院内感染的潜在源头。
2、“亦敌亦友”的双面角色
正常情况下,它与肠道菌群和平共处。但当肠道菌群失衡时,如长时间使用广谱抗生素尤其是克林霉素、第三代头孢菌素等药物。药物在杀灭致病菌的同时,可能误伤肠道有益菌群,导致菌群失衡。艰难梭菌趁机大量繁殖,释放毒素(肠毒素A/细胞毒素B)攻击肠黏膜,引发内源性感染。也可通过接触环境中的艰难梭菌芽孢,经“粪-口”途径传播,导致外源性感染。
3、高危人群:这些人要格外警惕!
①长期暴露于广谱抗菌药物患者
②有严重基础疾病患者
③老年人
④使用免疫抑制剂或免疫低下患者
⑤有胃肠手术史
⑥住院时间长的患者
4、感染症状:从腹泻到致命危机
艰难梭菌感染常以看似普通的消化道症状起病,患者可能出现发热、腹痛、腹泻(水样便)等表现。轻症者可能仅有轻微腹泻,但若放任不管,这种细菌可能引发致命危机——严重感染可导致伪膜性肠炎,甚至伴随中毒性巨结肠、肠穿孔、感染性休克等并发症,严重威胁生命。

5、如何揪出肠道“隐形杀手”
在确定是否有艰难梭菌的感染时,临床上通常同时进行艰难梭菌培养和艰难梭菌毒素检测。都是艰难梭菌相关检查,为什么要两种都检测呢?
①艰难梭菌培养:培养检测的敏感度较高,不易漏检。但它的局限性在于无法判断这些菌株是否具有产毒能力。检测到艰难梭菌的存在,不代表该菌株就是产毒素的致病菌,也有可能是无症状的肠道定植菌。
②艰难梭菌毒素检测:使用酶免疫分析法能够快速检测出艰难梭菌释放的毒素(肠毒素A/细胞毒素B),这种方法特异性强、能够准确区分产毒株和非产毒株,锁定真正的致病菌。但若毒素含量过低,可能出现漏检。
联合检测艰难梭菌培养和艰难梭菌毒素检测,既能避免过度治疗定植者又能防止低毒素含量的感染者漏诊。
6、检测结果矛盾了怎么办?
当两种检测结果不一致时,需结合患者症状综合分析:
①培养阳性+毒素阴性:可能是无症状定植,若无腹泻等症状,通常无需治疗。
②培养阴性+毒素阳性:可能患者已接受艰难梭菌抗感染治疗,导致细菌死亡,但残留毒素仍可被检测。需结合患者症状判断,若腹泻持续,可能需重复检测或改用艰难梭菌毒素检测的其他方法或者艰难梭菌毒素基因检测进行复查确认。
7、预防:守住肠道防线
①抗生素不滥用:遵医嘱用药,避免长期使用广谱抗生素。
②医院防控:腹泻患者需隔离,环境用含氯消毒液彻底清洁。
③手卫生:接触患者或医院物品后,及时用肥皂及流动水洗手。
8、治疗:精准打击,重建平衡。
医生改变了赵阿姨的治疗策略,停用原抗生素,改用口服万古霉素和甲硝唑有针对性的抑制艰难梭菌。同时补充益生菌,辅助恢复肠道菌群。赵阿姨经治疗后,多次复查艰难梭菌培养阴性,腹泻情况得到了有效控制,平稳出院。
总结
艰难梭菌是滥用抗生素时代的“典型反派”。维护肠道菌群平衡、规范用药、注重手卫生,是抵御它的关键。若出现抗生素相关腹泻,及时就医筛查,早诊断、早治疗,才能避免严重后果。
参考文献:
[1] 中国艰难梭菌医院感染预防与控制指南 [J]. 中华医院感染学杂志, 2018, 28 (23): 3674-3680.
[2] 徐英春,张曼. 中国成人艰难梭菌感染诊断和治疗专家共识[J]. 协和医学杂志,2017,8(2):131-138. DOI:10.3969/j.issn.1674-9081.2017.03.011.
[3] 临床微生物检验问与答/张秀珍,朱德妹主编.-2版.-北京:人民卫生出版社,2014ISBN978-7-117-18801-2.
[4] 中国艰难梭菌感染诊治及预防指南(2024)中华医学会外科学分会,中国研究型医院学会感染性疾病循证与转化专业委员会中华医学会外科学分会,中国研究型医院学会感染性疾病循证与转化专业委员会中国艰难梭菌感染诊治及预防指南(2024)《中华外科杂志》2024,62(10)

北京清华长庚医院APP
快速挂号